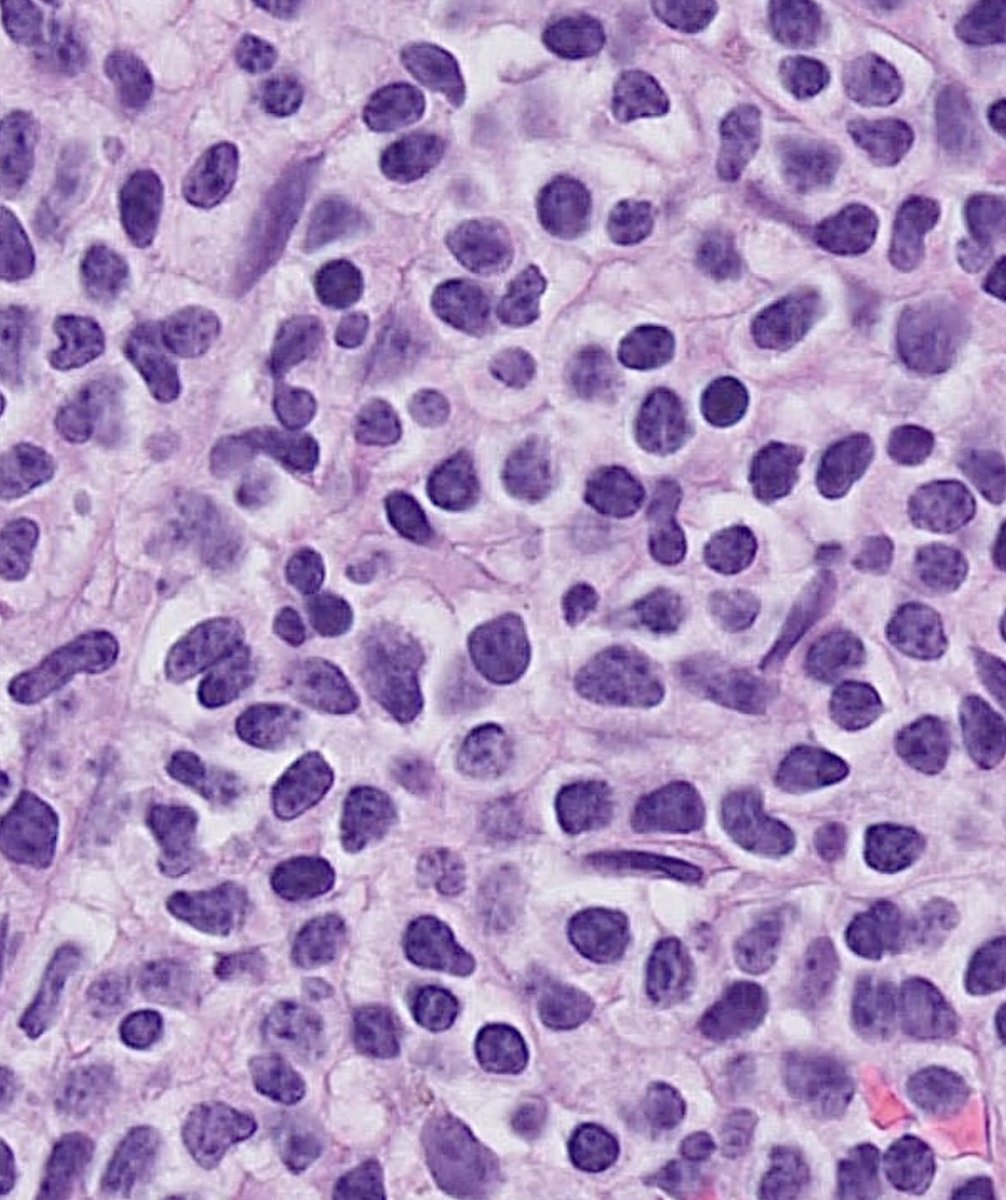
Tiger_heme's tweet image. BMB 41 yo male. All these cells are positive for CD3, CD5, CD2, CD7. In the pics you can see the CD4 and CD8. What is your diagnosis? What other stains would you like to see?
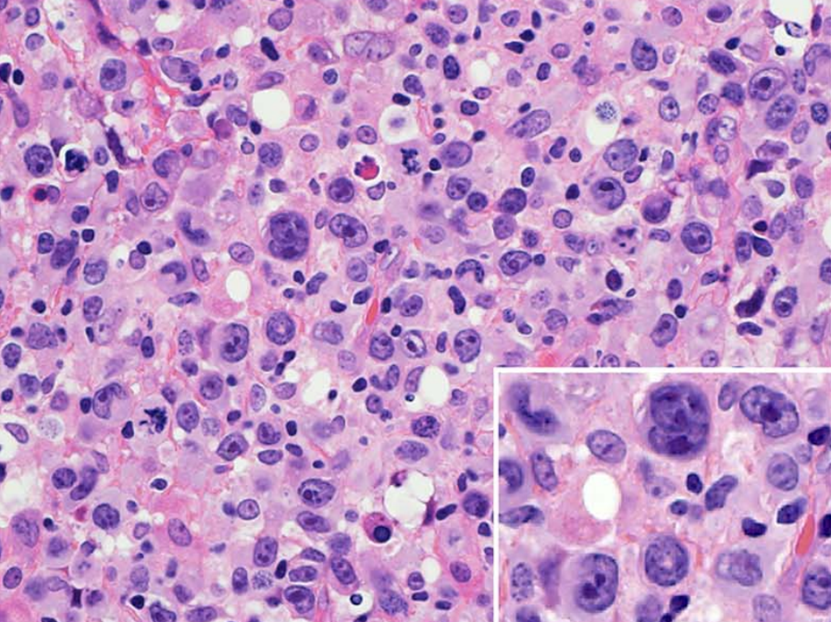
SibaElHussein's tweet image. 🩸Continuing with the theme of ALCL-mimickers, extranodal NK/T-cell with anaplastic morphology is an underrecognized variant that seems to be highly aggressive &amp;amp; potentially misdiagnosed

🩸Below is a photo of a case of extranodal NK/T-cell lymphoma with a striking anaplastic…
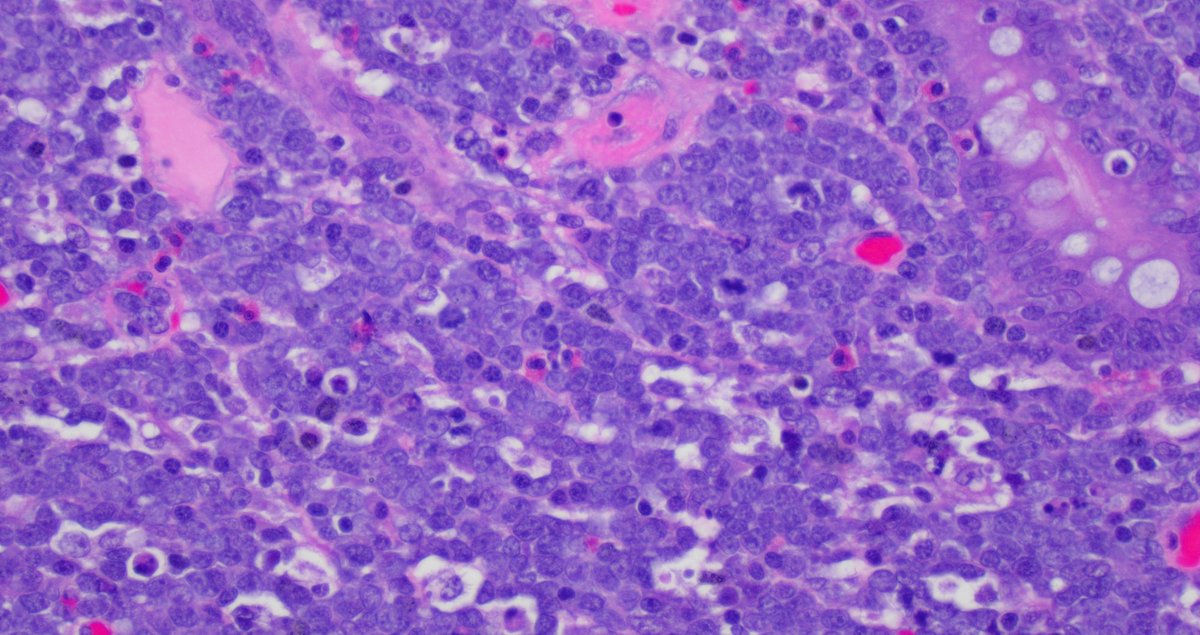
SibaElHussein's tweet image. Illustration of a case of Burkitt lymphoma in the intestine with characteristic variable/ patchy SOX11 expression pattern. SOX11 may come in handy in tricky cases when you need more evidence to push for Burkitt lymphoma vs other mimickers #hemepth #lmsm #pathtwitter #PathX #MedX
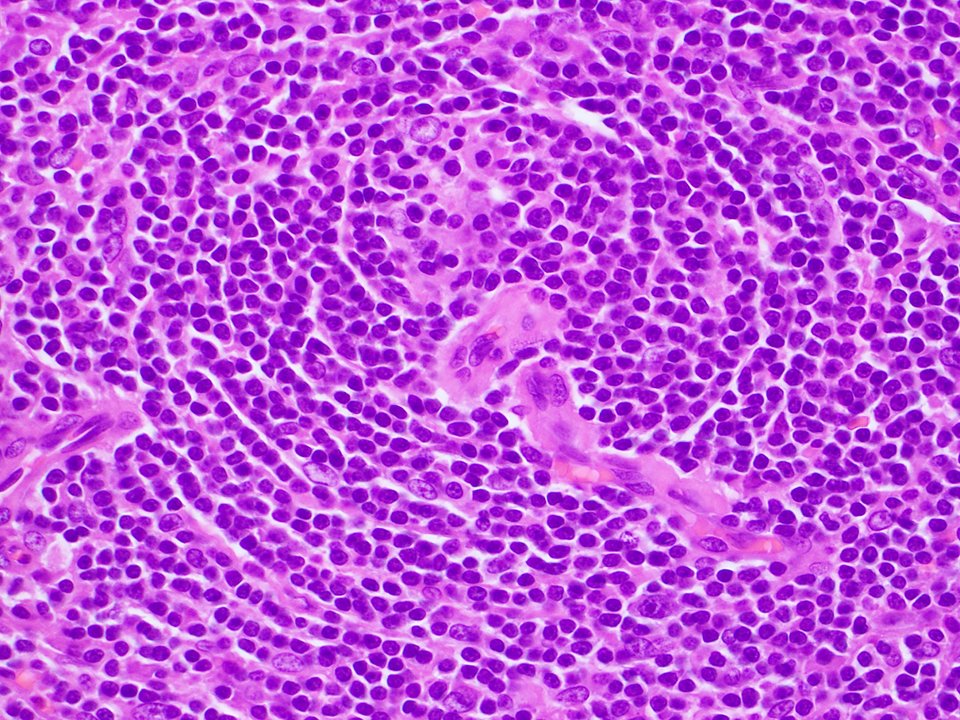
SibaElHussein's tweet image. Unicentric Castleman disease-plasma cell variant:Preserved overall lymph node architecture and marked plasmacytosis in interfollicular areas,with a subset germinal centers showing regressive changes reminiscent of Castleman disease-hyaline vascular variant #Hemepath #HemepathMDA
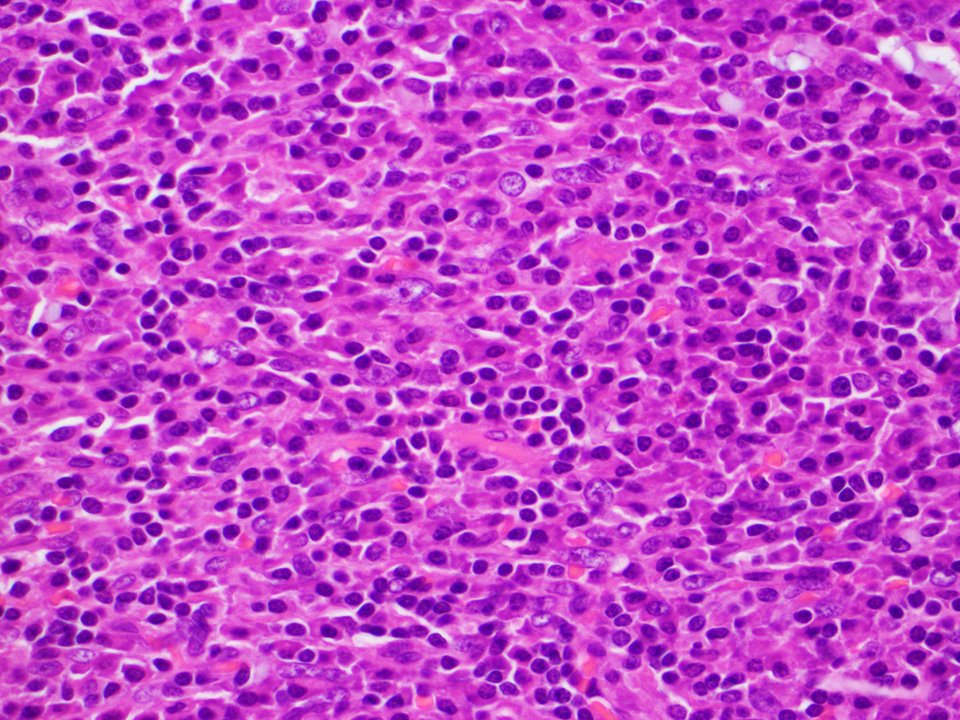
SibaElHussein's tweet image. Unicentric Castleman disease-plasma cell variant:Preserved overall lymph node architecture and marked plasmacytosis in interfollicular areas,with a subset germinal centers showing regressive changes reminiscent of Castleman disease-hyaline vascular variant #Hemepath #HemepathMDA
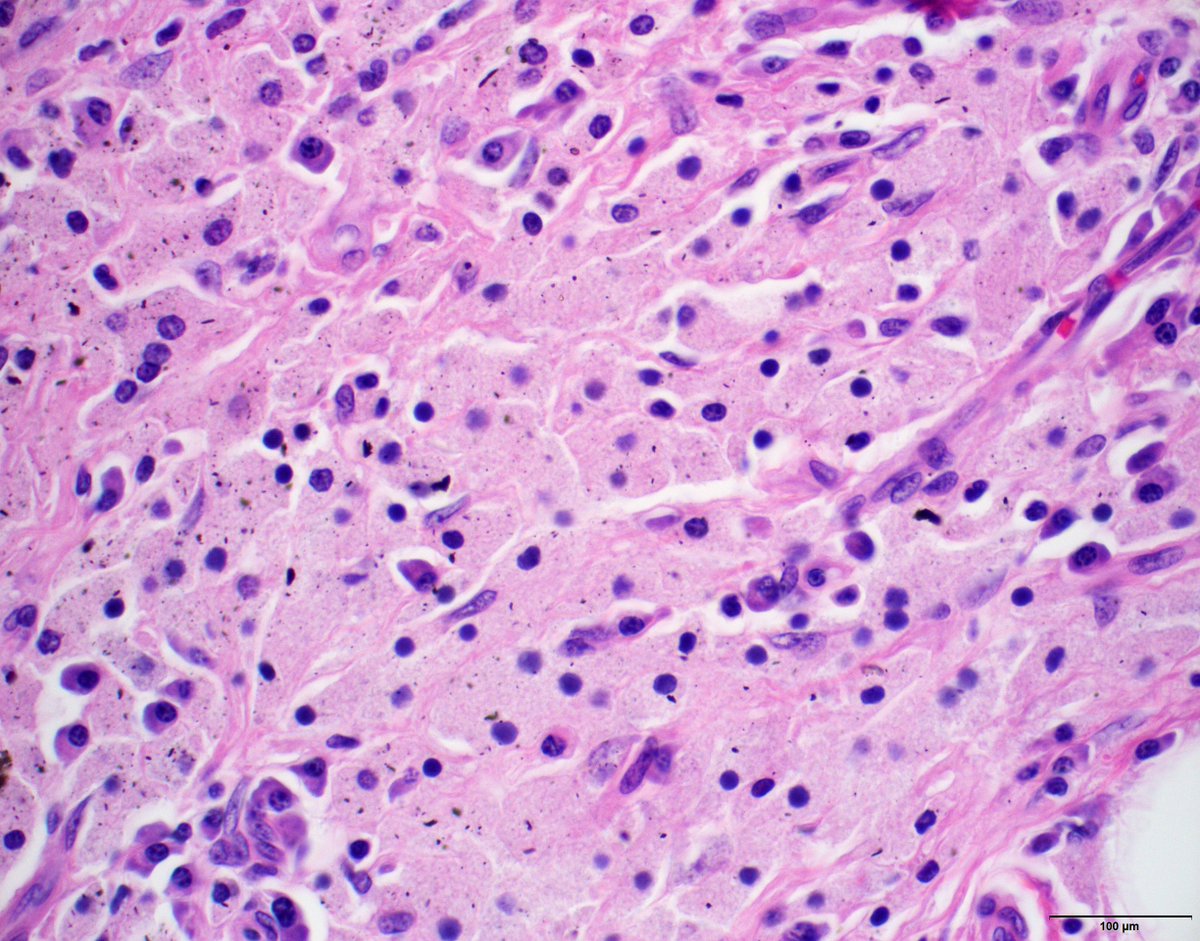
KyleBradleyMD's tweet image. What do you see in the interfollicular region of this lymph node?

What is the most likely etiology for this finding?

#hemepath
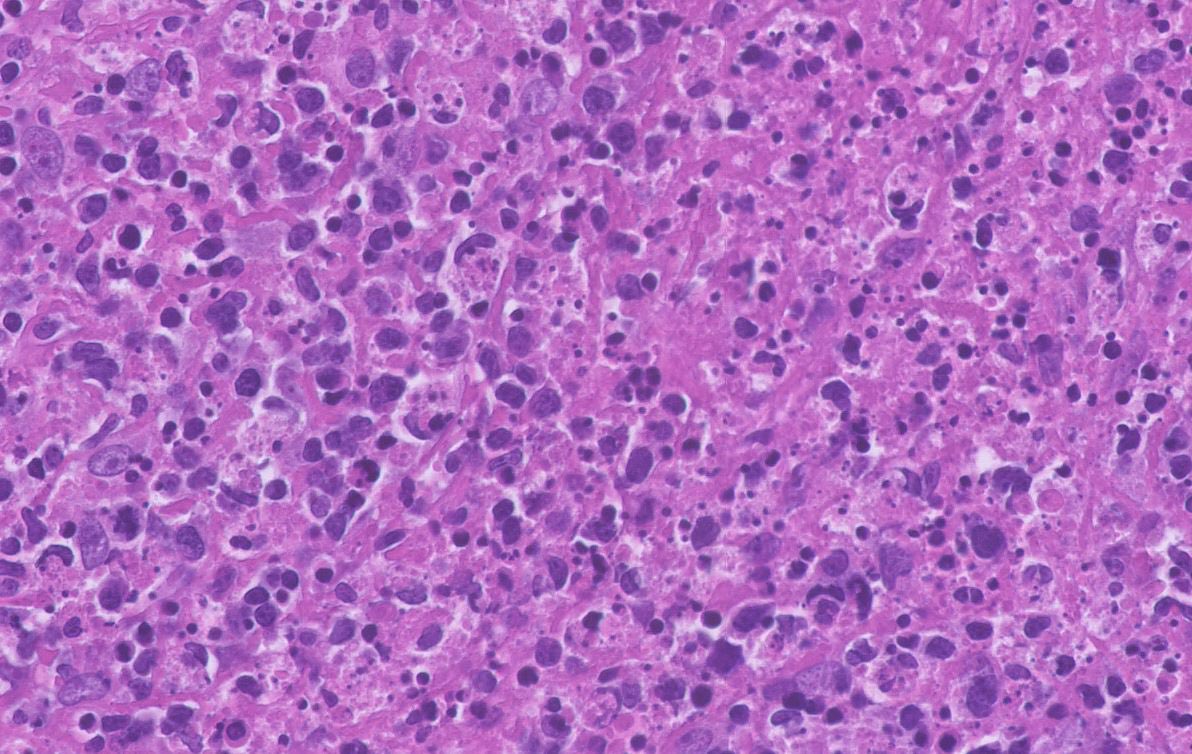
Tiger_heme's tweet image. Axillary LN, 29 yo woman. What are the arrows pointing at?
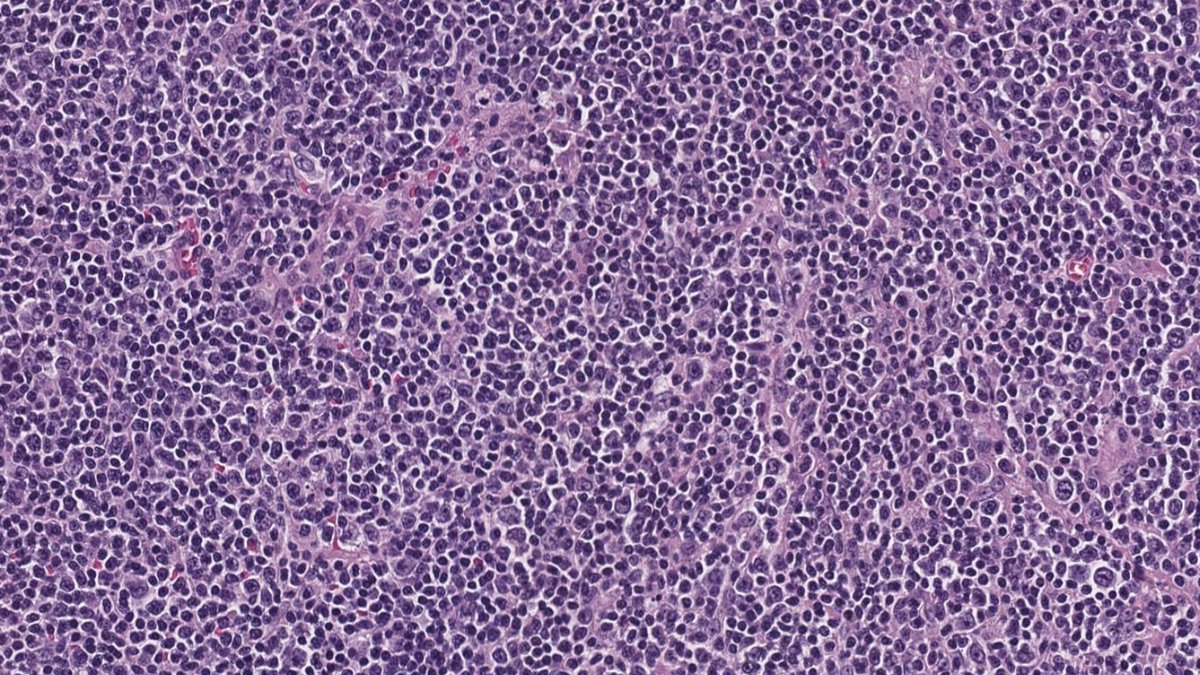
SibaElHussein's tweet image. Follicular lymphoma with BCL2 rearrangement by FISH &amp;amp; unusual overexpression of CCND1 by IHC (CD5 &amp;amp; SOX11 negative; CCND1 rearrangement negative by FISH). This rare finding has been reported previously➡️shorturl.at/lzDOU but is worth to be aware of #hemepath #lymsm #PathX

Tamara Zudaire
@LangerPath
#Pathologist 🔬 Always and forever learning. Hospital San Pedro. #CytoPath #HemePath #EndoPath
Bunları beğenebilirsin
Ferruginous bodies in BAL. Dumbbell-shaped, golden yellow to black with Pap, blue with Perls an golden yellow with H&E. Happy to have seen them for the first time outside of the books! 😁 #cytopath #cytology



70 yo M no relevant PMH. Buccal mucosa ulcer biopsy (see H&E). Waiting on GMS. Do you buy cryptococcus? @ParasiteGal @LangerPath



BMB 41 yo male. All these cells are positive for CD3, CD5, CD2, CD7. In the pics you can see the CD4 and CD8. What is your diagnosis? What other stains would you like to see?

More on anaplastic large cell lymphoma (ALCL) mimickers: Enteropathy associated T-cell lymphoma (EATL) may exhibit anaplastic morphology, with pronounced inflammatory background consisting of histiocytes, eosinophils, small lymphocytes, and plasma cells. Furthermore, EATLs with…

🩸Continuing with the theme of ALCL-mimickers, extranodal NK/T-cell with anaplastic morphology is an underrecognized variant that seems to be highly aggressive & potentially misdiagnosed 🩸Below is a photo of a case of extranodal NK/T-cell lymphoma with a striking anaplastic…

Illustration of a case of Burkitt lymphoma in the intestine with characteristic variable/ patchy SOX11 expression pattern. SOX11 may come in handy in tricky cases when you need more evidence to push for Burkitt lymphoma vs other mimickers #hemepth #lmsm #pathtwitter #PathX #MedX

Unicentric Castleman disease-plasma cell variant:Preserved overall lymph node architecture and marked plasmacytosis in interfollicular areas,with a subset germinal centers showing regressive changes reminiscent of Castleman disease-hyaline vascular variant #Hemepath #HemepathMDA

What do you see in the interfollicular region of this lymph node? What is the most likely etiology for this finding? #hemepath

Axillary LN, 29 yo woman. What are the arrows pointing at?

Follicular lymphoma with BCL2 rearrangement by FISH & unusual overexpression of CCND1 by IHC (CD5 & SOX11 negative; CCND1 rearrangement negative by FISH). This rare finding has been reported previously➡️shorturl.at/lzDOU but is worth to be aware of #hemepath #lymsm #PathX

Relapsed classic Hodgkin lymphoma (CHL) with brighter PAX5 expression then typically accepted for CHL, and associated new emerging follicular lymphoma in the same lymph node biopsy (bottom right of Figure 1) #hemepath #lymsm #pathX #MedX #SoMe #Surgpath #MedTwitter #Pathtwitter




Follicular lymphoma with abundant extracellular eosinophilic material, mimicking amyloid deposition: An unsual variant to be aware of #hemepath #lymsm #pathtwitter #MedEd #SoMe Check a similar but more prominent case by @sanamloghavi @BloodJournal➡️ ashpublications.org/blood/article/…




Large B-cell lymphoma involving the testicle with a germinal center-like phenotype (CD10+BCL6+MUM1-): May occur in < 10% of primary large B-cell lymphoma of the testis, however, it should raise the suspicion of disseminated systemic DLBCL #hemepath #lymsm #surgpath #Pathx #MedX




Primary large B-cell lymphoma of the CNS: Cyclin-D1 highlights endothelial cells in brain tissue, however its pattern of expression could be misinterpreted as positivity in neoplastic cells. Comparison to MUM1 & PAX5 is helpful to avoid this pitfall #hemepath #lymsm #PathX




Salivary gland "Acinic Cell Carcinoma" may occasionally assumes a very "histiocytic" appearance on FNA, as nicely shown in this case. DD in such scenario includes - Mucoepidermoid CA, Secretory CA, Metastatic RCC and Benign cyst with macrophages.


Definitely the best example of ☢️radiation colitis☢️ I've ever seen. Angiectatic vessels are so prominent; they even show superficial thrombi. #GiPath #Pathology



What would you call this lesion in the cervical biopsy?? #pathology




One adrenal is from a patient with an endocrine disorder, the other adrenal has normal histology (an innocent bystander removed as part of ambitious surgery for unrelated purposes). Let's hear it in the polls below!


70ish y/o male, gastric lesion, excision. Tumor is locaded in the submucosa, with infiltrative growth to the subserosal layer. Cells are arranged in solid sheets. Monomorphic appearance. Let's have a closer look! Follow the thread... 🧵


Hello Friends, I have the pleasure of sharing with you some of my best photos of ferruginous bodies. We do not see the fiber around which it has formed. There are multinucleated macrophages that have either formed it or try to phagocytize it #ferruginousbodies #ferruginous #BAL

Pancreatic mass. Diagnosis? A) Non-diagnostic B) Negative (for malignancy) C) Neoplastic (benign or other) D) Malignant #cytopath #pathology #gipath #pathtwitter


Beautiful fruiting heads, isn’t it? I had to stop for a few minutes and appreciate their beauty🤍

United States Trendler
- 1. Joe Brady N/A
- 2. Holocaust N/A
- 3. Daboll N/A
- 4. Aaron Glenn N/A
- 5. Philip Glass N/A
- 6. Babich N/A
- 7. #DaredevilBornAgain N/A
- 8. #ValentinoSpeculaMundi N/A
- 9. Jimmy Kimmel N/A
- 10. #Olandria N/A
- 11. Engstrand N/A
- 12. Doomsday Clock N/A
- 13. Cam Ward N/A
- 14. Aaron Judge N/A
- 15. Vindman N/A
- 16. Juan Crow N/A
- 17. Taxation N/A
- 18. Rick Rizzs N/A
- 19. Jessica Jones N/A
- 20. Megyn Kelly N/A
Bunları beğenebilirsin
-
 Rosalinda Peñaloza
Rosalinda Peñaloza
@rositadeolivop1 -
 Med Amine
Med Amine
@EssaoudiMohamed -
 María Cámara Jurado MD, PhD
María Cámara Jurado MD, PhD
@mcamarajurado -
 gulcin guler simsek, MD
gulcin guler simsek, MD
@glinglerimek -
 Christina Zioga
Christina Zioga
@chriszioga -
 aung phyo
aung phyo
@pathphyo -
 June
June
@flr7066 -
 Miriam Keiko
Miriam Keiko
@mitakehara -
 Ankur Singh, DNB (Path)
Ankur Singh, DNB (Path)
@ankspath -
 Isidro Machado MDPhD
Isidro Machado MDPhD
@MachadoIsidrin -
 Efrosini Iacovou
Efrosini Iacovou
@EIacovou -
 Yaroslav Brygadyr
Yaroslav Brygadyr
@YaBrygadyr -
 Sarra Ben Rejeb
Sarra Ben Rejeb
@SbrSarra -
 Karen Ferrer, MD
Karen Ferrer, MD
@plessthanpt001
Something went wrong.
Something went wrong.
















































































































































